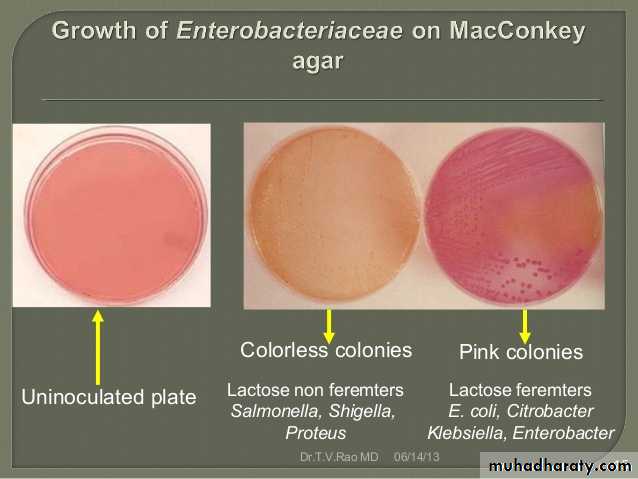
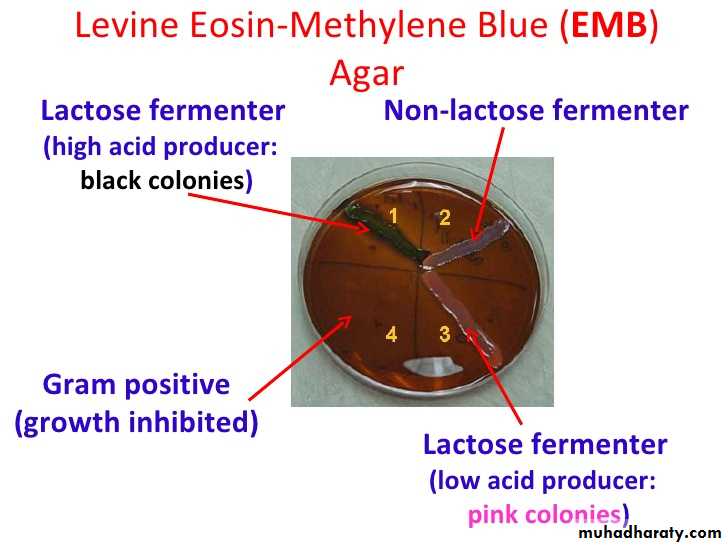
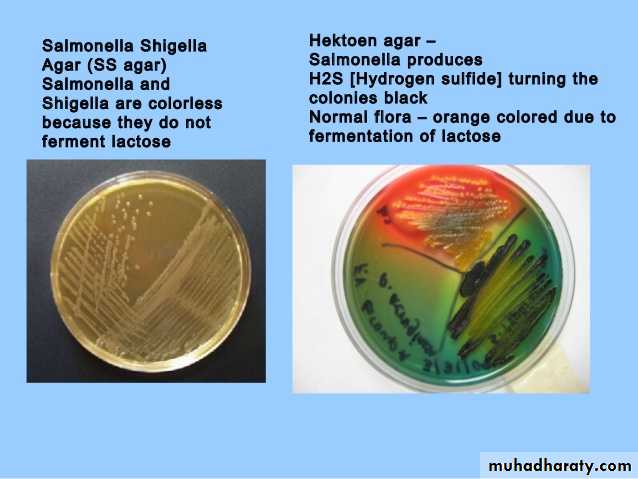
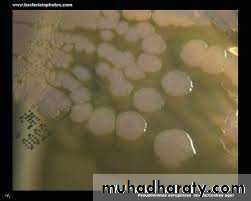
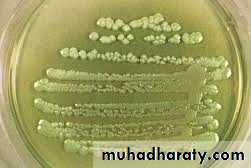
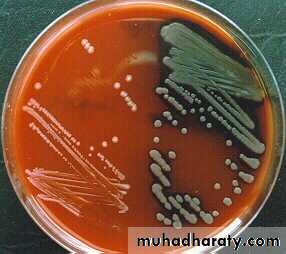
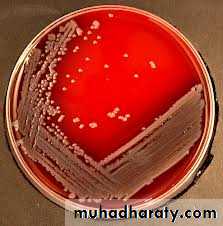
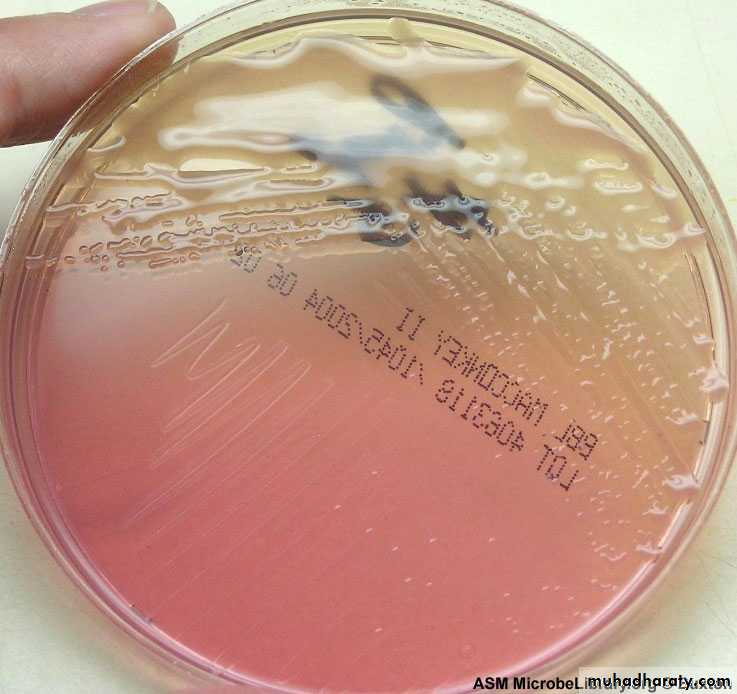
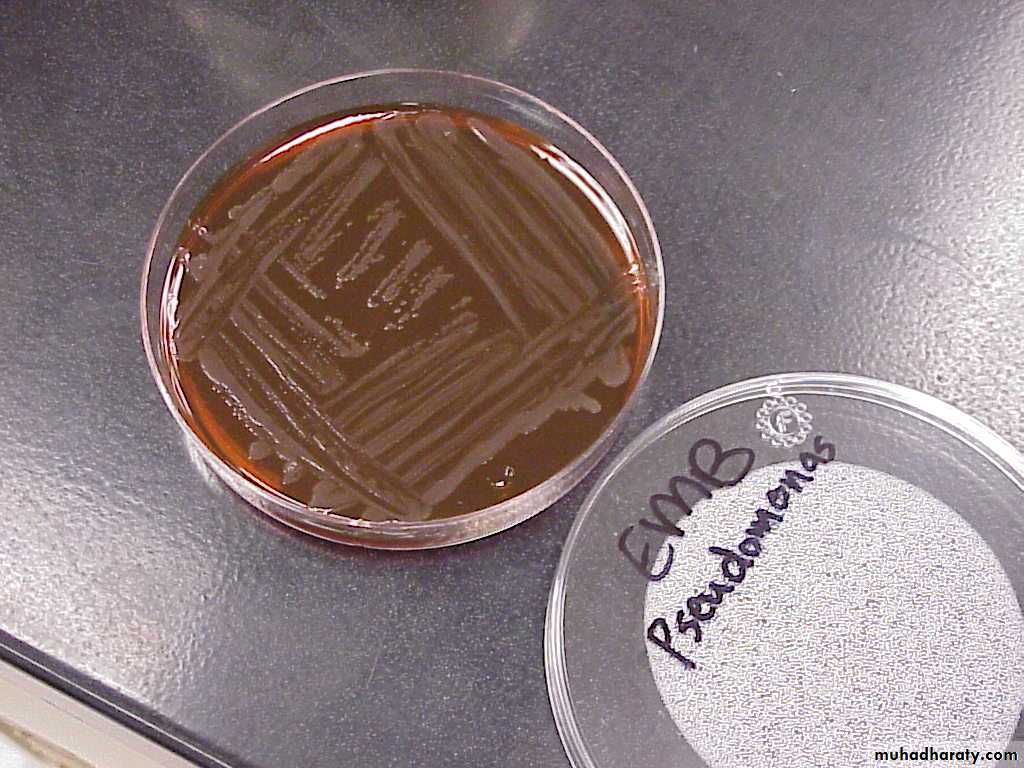
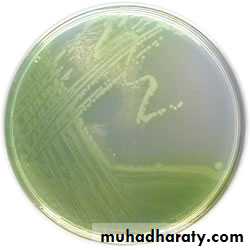

Enterobacteriaceae
MSc. Sarah Ahmed• Oxidase Test
PositiveNegative
Pseudomonas
EnterobacteriaceaeIdentification of Gram's -ve rods
Nitrate test: +ve furtherreduction to N2
Growth on cetrimide agar:
Pale colonies with green
pigmentation
MacConkey’s agar
& TSI
Lactose fermenter
Pink colonies on MacConkey& acidic butt and slant on TSI
colorless colonies on MacConkey
& acidic butt alkaline slant onTSI
Lactose non-fermenter
IMViC test& EMB
IMViC
++ - -& black colonies with metalic shines on EMB
E.coli
IMViC- - ++
Klebsiella
No H2S production Y/R
(no blacking in TSI)
Y/R H2S production
(blacking in TSI)
Shigella
Urease production+ve
Proteus
-veSS agar
colorless colonies with black centersSalmonella
O/F test: O+/F-Motility
Not motile
Motile
EnterobacterCulture character
Form smooth and round colonies.Fluorescent greenish colour.
production of fruity odor (grape-like) .
Inability to ferment lactose.
• Pseudomonas
On nutrient agarColonies are smooth, large, translucent
Greenish blue diffusible pigment
On blood agar
Grayish coloniesMany are haemolytic
(beta hemolysis).
This picture shows Pseudomonas aeruginosa (on the right) and Shigella dysenteriae (on the left) in blood agar.
On MacConkey agar
Non-lactose fermenting (colourless colonies)On EMB
Non lactose fermentingCetrimide agar
is a type of agar used for the selective isolation of the gram-negative bacterium, Pseudomonas aeruginosa.As the name suggests, it contains cetrimide, which is the selective agent against alternate microbial flora.
show a characteristic blue-green and yellow-green colour, respectively.